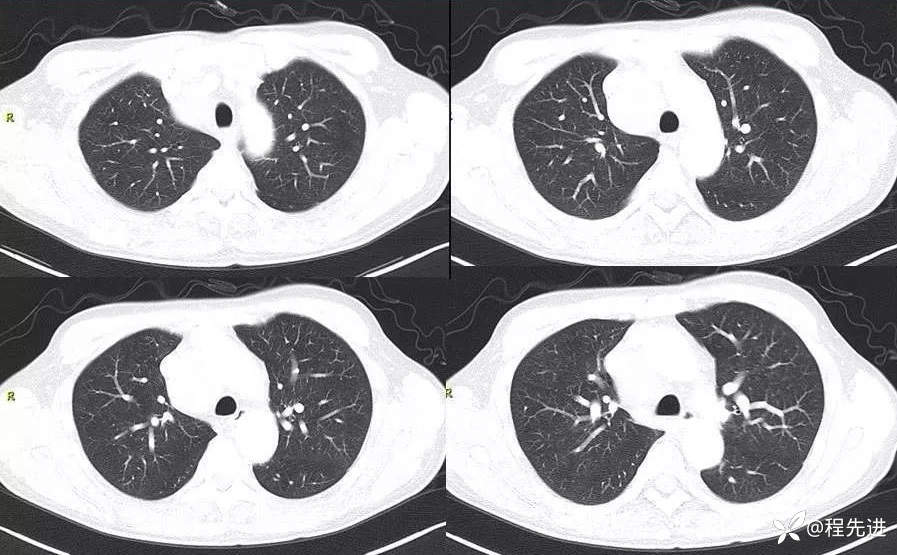
img

2023国庆特别精彩病例(五)|中纵隔占位,影像资料齐全,期待你的挑战|病理已公布
 呱呱叫了 等 3 位达人已点赞
呱呱叫了 等 3 位达人已点赞患者性别:男
患者年龄:62岁
病史:暂时隐藏(公布结果时开放病史)
CT
增强动脉期横断位

增强静脉期冠状位

增强静脉期矢状位

肺窗

MR
T2

T2压脂

T2冠状位

T2矢状位

DWI

ADC

T1+C 动脉增强

期待你的精彩分析!
 呱呱叫了 等 3 位达人已点赞
呱呱叫了 等 3 位达人已点赞患者性别:男
患者年龄:62岁
病史:暂时隐藏(公布结果时开放病史)
CT
增强动脉期横断位

增强静脉期冠状位

增强静脉期矢状位

肺窗
MR
T2

T2压脂

T2冠状位

T2矢状位

DWI

ADC

T1+C 动脉增强

期待你的精彩分析!
